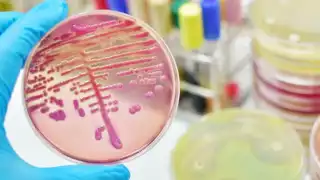
Esta bacteria es resistente a varios antibióticos

Las autoridades de salud federal han informado sobre un brote de la bacteria Klebsiella oxytoca que ha afectado al menos a 20 niños en el Estado de México, de los cuales 13 lamentablemente perdieron la vida.
Este brote se detectó en cuatro hospitales, tres públicos y uno privado, donde la infección podría estar vinculada a la contaminación en soluciones de nutrición parenteral (NPT), utilizadas para alimentación intravenosa.
Detalles del brote y medidas tomadas
El brote, reportado por primera vez el 5 de diciembre, provocó la hospitalización de siete pacientes que permanecen bajo tratamiento, con resultados negativos en sus cultivos tras recibir atención médica.
La Comisión Federal para la Protección contra Riesgos Sanitarios (Cofepris) suspendió a la empresa proveedora de los insumos relacionados con la NPT. Asimismo, inmovilizó los lotes producidos desde el 21 de noviembre y realizó inspecciones en la central de mezclas responsable, concluyendo que no había hallazgos críticos en sus instalaciones.
Noticia Destacada
Klebsiella oxytoca: Esto es lo que sabe de la bacteria que le arrebató la vida a menores en Estado de México
El Instituto de Diagnóstico y Referencia Epidemiológica (InDRE) aisló bacterias en muestras humanas y de las soluciones parenterales, lo que permitirá analizar el origen exacto de la contaminación.
Reacciones del Gobierno Federal
La presidenta de México, Claudia Sheinbaum, se comprometió a investigar las causas de este brote y aseguró que se tomarán medidas contundentes para evitar que tragedias similares vuelvan a ocurrir.
Riesgos asociados a Klebsiella oxytoca
Esta bacteria, frecuentemente reportada en hospitales, causa infecciones en las vías urinarias y biliares. Es particularmente peligrosa para pacientes vulnerables, como aquellos con enfermedades crónicas o que han recibido antibióticos previamente.
Alerta nacional
Los fallecimientos han encendido las alarmas en el Estado de México, el más poblado del país. Las autoridades han intensificado las medidas de vigilancia epidemiológica y exhortan a la población a mantenerse informada a través de fuentes oficiales.
IO






